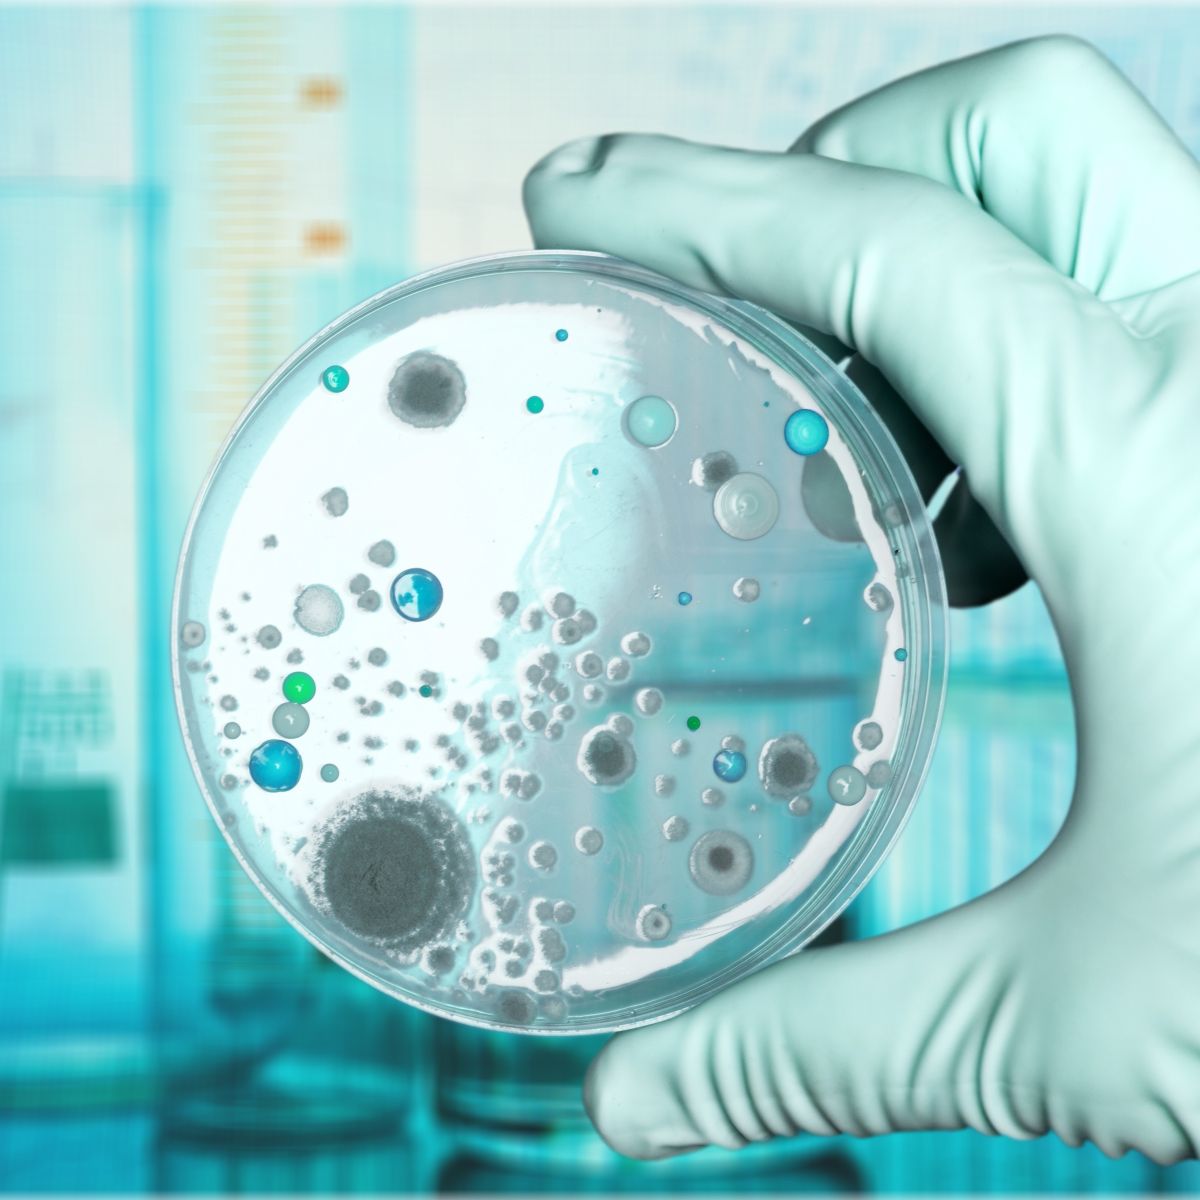
Image

- fas fa-search
- Accessibility
Molekuláris alapokon nyugvó mikrobiológiai vizsgálatok víz- és talajminták esetében
Szolgáltatási kör leírása
Cél: vízkezelő rendszerek minőségi ellenőrzése, illetve talaj állapot felmérése.
A vízkezelési eljárások során használt membránok felületén létrejövő mikrobiológiai közösség felmérése, azonosítása molekuláris biológiai módszerekkel. A minták koncentrálása és nukleinsav kivonása majd a DNS mennyiségi meghatározása, hogy az adott technológiában mely mikroorganizmusok károsítanak.
Kommunális szennyvízminták monitorozása különböző patogén mikroorganizmusokra fókuszálva.
Talajok mikrobiológiai közösségének DNS szintű vizsgálata, a talaj minőségének felmérésére egyéb paraméterek szerint.

Adamcsik Orsolya

Dr. Kesserű Péter
Szolgáltatások
01
Víz minőségi vizsgálatok (mikrobiológiai paraméterek: telepszám meghatározás)
02
Membrántechnológiai mérések
03
Kommunális szennyvíz vizsgálata - SARS-CoV-2 és Adenovírus kimutatása, kvantitatív polimeráz lánreakció (qPCR) készülék segítségével.
Talajvizsgálatok:
4
Szárazanyag-tartalom mérése
06
Nedvességtartalom meghatározása
07
Szerves - szervetlen alkotók meghatározása
08
Vízmegkötő képesség vizsgálata
09
Arany-féle kötöttségi szám meghatározása
10
A talajok kémhatásának vizsgálata
11
Humusztartalom meghatározása
12
Talaj karbonát- és hidrokarbonát ion tartalmának meghatározása
13
Talaj savanyúságának meghatározása (hidrolitos és kicserélhetőségi savanyúság)
Miért válassza a Pannon Egyetemet?
Kutatási és fejlesztési kompetenciáinkkal valódi értéket teremtünk vállalati partnereink számára.
Infrastruktúra
- OHAUS centrifugák: amelyeknek előnye, hogy cserélhető rotorral rendelkeznek, így különböző mennyiségű folyadék centrifugálható.
- Ultramély hűtő: -80°C -on érzékeny biológiai minták hosszútávú tárolására alkalmas. A biológiai aktivitás és az örökítőanyag bomlásának minimalizálása érdekében szükséges az alacsony hőmérséklet.
- PCR fülke: biztosítja a steril levegő áramoltatásával, hogy a minta feldolgozása során nem kerül bele szennyező, nukleinsav bontó anyag.
- UV fülke: az UV fény csíramentesítő hatása és a levegő cirkulálása a minta kontaminációját minimalizálja. A PCR reakcióhoz szükséges reagensek biztonságos összemérése lehetséges.
- NanoPhotometer (IMPLEN N50): A NanoPhotométer készülékkel lehetséges az előkészített minta koncentrátumban megmérni az össznukleinsav tartalmat, ng/µl mértékegységben adja meg a koncentrációt.
- POL-EKO ILW 115 SMART hűthető inkubátor, ventilátor szabályozással: Több szabványos funkcióval rendelkezik, eltérő hőmérsékleti tartományokkal. Az inkubátor alkalmas különböző minták megfelelő hőmérsékleten való tárolására. Több áramforrás is megtalálható a belső térben, így mágneses keverők elhelyezésével a minta kevertetésére is van lehetőség. Több szintre helyezhetők, kivehetők a polcok, így az optimális magasság is beállítható mintától, mintatartó edénytől függően.
- Autokláv (Tuttnauer), modell: 3850 EL: Kamra térfogata: 65 liter. Max megengedhető nyomás: 2,8 bar. Különböző alap programok találhatóak meg a készülékben.
- Szárítószekrény (MMM) Venticell 55: Paraméterek: használható belsőtér kb. 55 liter. Műszaki adatok: belső rész rozsdamentes acél, szélesség: 400 mm, mélység: 390 mm, magasság: 350 mm. Tálcák elhelyezhetők a belső térben: maximális terhelhetőségük: tálcánként: 20 kg/tálca, teljes terhelés: 50 kg/egység.
Hőmérsékleti adatok (üzemi hőmérséklet):
- standard típusnál: legfeljebb 250 °C,
- opcionális típusnál 300°C-ig.
A szárítószekrény alkalmas eszközök sterilizálására, illetve minta előkészítési folyamatokban a szárítás/felmelegítés lehetséges.
- Mikroszkópok: Marrone power-től kapott fénymikroszkóp, Maximum 400x-os nagyításra képes. Tárgylemezen lévő minta automata feltérképezése, kézi vezérlés is lehetséges, 3 féle objektívvel rendelkezik (40x, 80x, 100x). Mikroszkóphoz csatlakozó számítógép és program segítségével a mintákról fénykép készíthető. Pl: szennyvíz iszap minták vizsgálhatók.
Sztereo mikroszkóp nagyítása 4x és 2x. Nagyobb méretű minták vizsgálatára alkalmas.
- BioRad CFX Opus 96 qPCR készülék: az előkészített, koncentrált minták nukleinsav tartalmának kvantitatív meghatározására alkalmas.
Referenciák
- MOL Nyrt. telephelyi szennyvízvizsgálatok, Nagykanizsa vonzáskörzetéhez tartozó kisebb települési önkormányzatok kérésére végzett szennyvízminták elemzése, lakossági kútvíz víz minőségi vizsgálata.
- COVID projekt: 2020-2.1.1-ED-2020-00014 COVID-19 vírus terjedésének, jelenlegi állapotának és lecsengésének vizsgálata a különböző szennyvizek elemzésével
Partnerek: Pannon Egyetem, Pécsi Tudományegyetem
- Befektetés a Jövőbe projekt: 2020-1.1.6-JÖVŐ-2021-00007 Gasztroenterális vírusok terjedésének korai előrejelző- és tájékoztató rendszerénekkidolgozása, szennyvíz alapú epidemiológiai megközelítéssel
Projekt partnerek: Pannon Egyetem, Pécsi Tudományegyetem, Asseco Central Europe Magyarország Zrt.
- Asseco KFI: 2020-1.1.2-PIACI-KFI-2020-00045 Kollaboratív kórházi információs platform folyamat- orientált fekvőbeteg- szakellátást támogató medikai rendszer létrehozása
Partnerek: Asseco Central Europe Magyarország Zrt., Pannon Egyetem, Dél-Pesti Centrumkórház
A projektek keretén belül különböző szennyvíz vizsgálatok történtek, különböző vírusok mennyiségi detektálására.
Kulszavak
Szennyvíz, vízminőség, talajmikrobiológia, membrántechnológia, nukleinsav